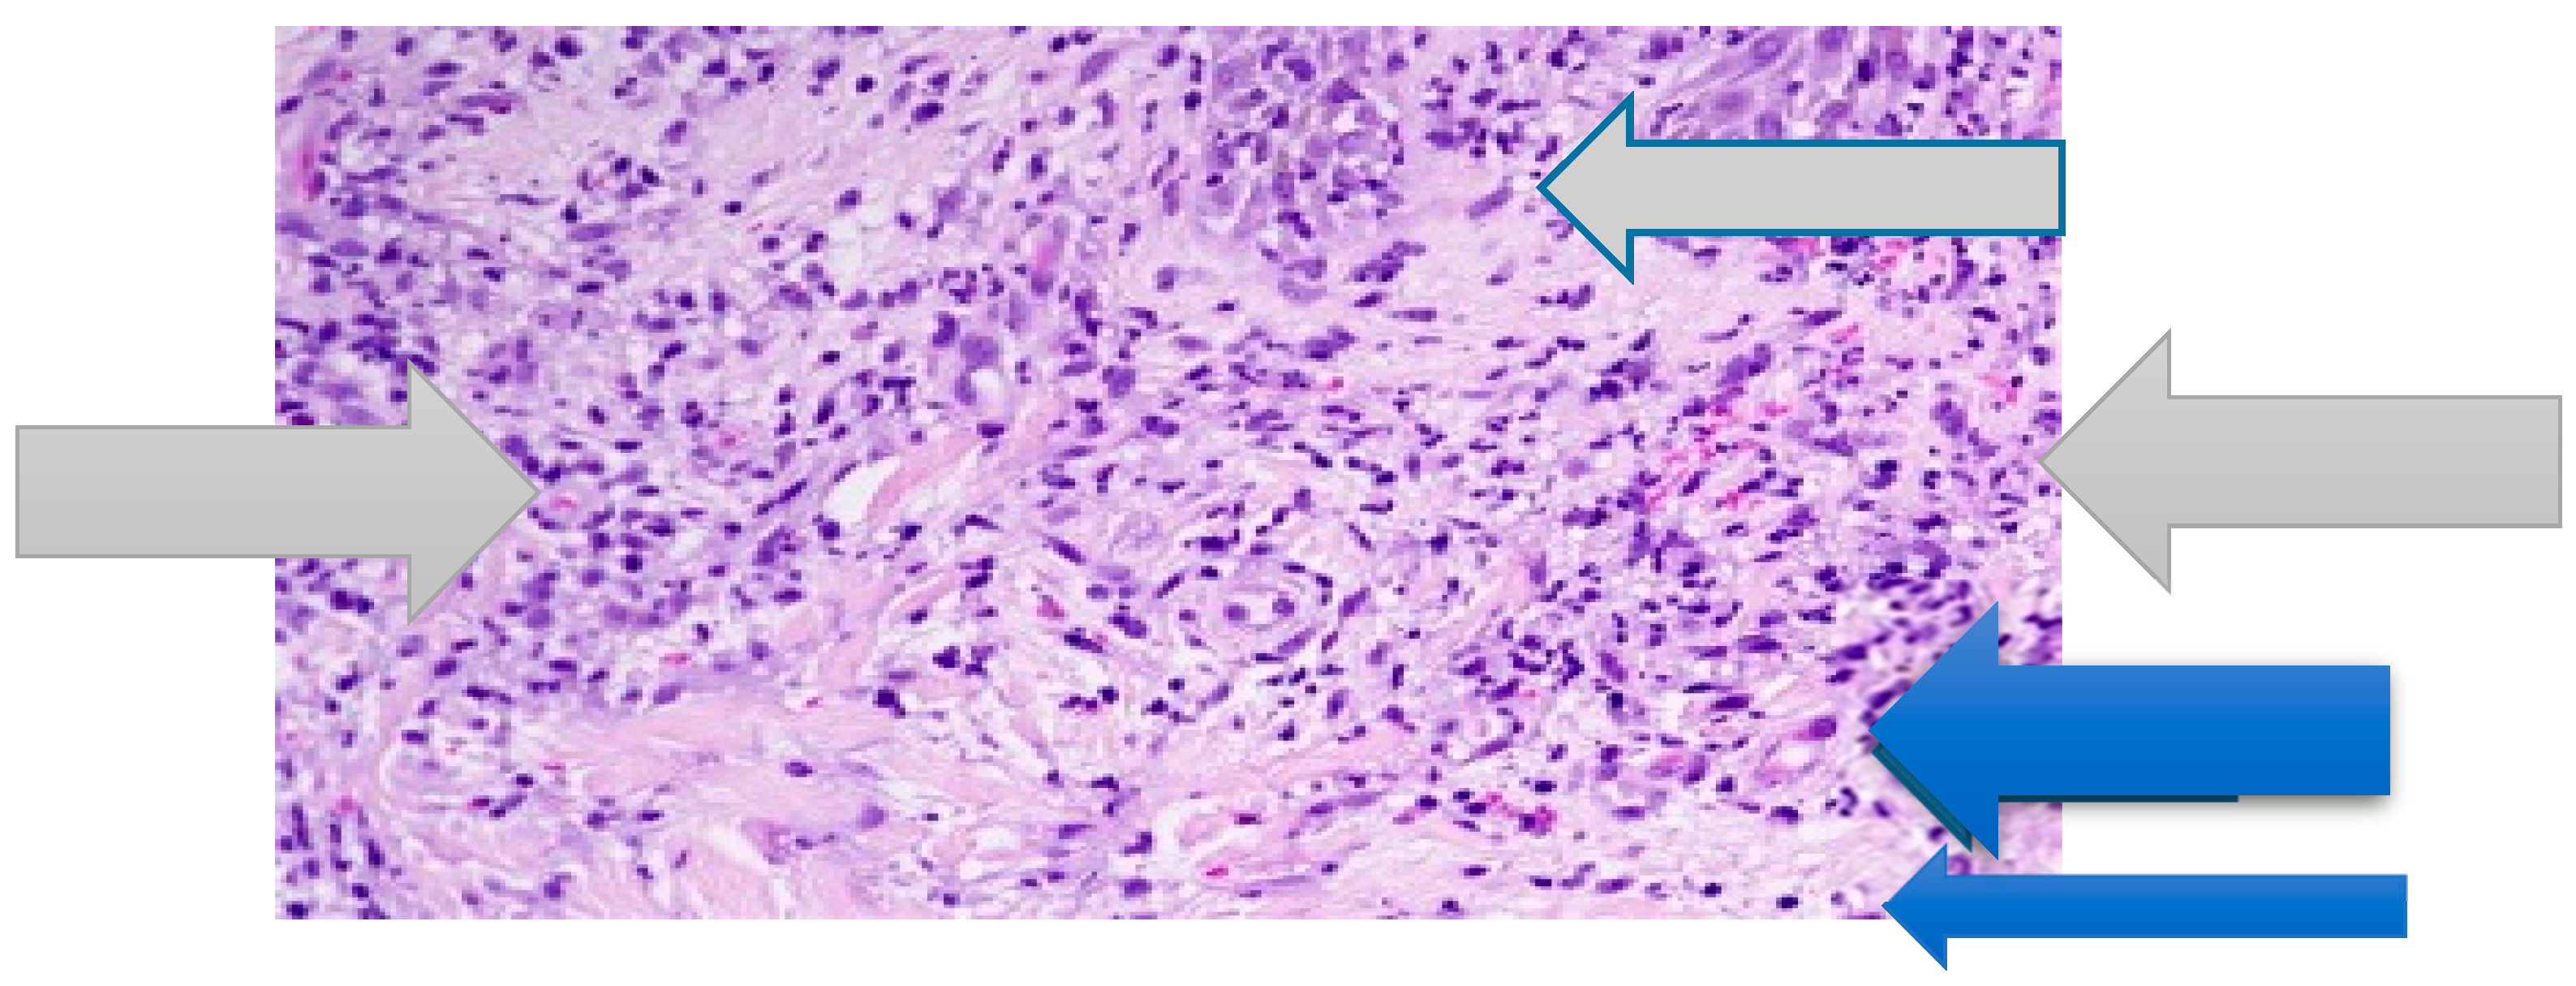
Medicines 06 00111 g002

Sweet’s Syndrome Following Therapy with Hydroxychloroquine in a Patient Affected with Elderly-Onset Primary Sjogren’s Syndrome
Abstract
1. Introduction
2. Case Report
3. Literature Review
4. Discussion
5. Conclusions
Author Contributions
Funding
Conflicts of Interest
Consent for Publication
References
- Cohen, P.R. Sweet’s syndrome—A comprehensive review of an acute febrile neutrophilic dermatosis. Orphanet J. Rare Dis. 2007, 2, 34. [Google Scholar] [CrossRef] [PubMed]
- Marzano, A.V.; Ortega-Loayza, A.G.; Heath, M.; Morse, D.; Genovese, G.; Cugno, M. Mechanisms of Inflammation in Neutrophil-Mediated Skin Diseases. Front. Immunol. 2019, 10, 1059. [Google Scholar] [CrossRef] [PubMed]
- Sweet, R.D. An acute febrile neutrophilic dermatosis. Br. J. Dermatol. 1964, 76, 349–356. [Google Scholar] [CrossRef] [PubMed]
- Heath, M.S.; Ortega-Loayza, O. Insights into the pathogenesis of Sweet’s syndrome. Front. Immunol. 2019, 10, 414. [Google Scholar] [CrossRef]
- Lopes Cacola, R.; Soares, M.; Cardoso, C.; Furtado, A. Seet’s syndrome complicating ulcerative cfolitis: A rare association. BMJ Case Rep. 2016. [Google Scholar] [CrossRef]
- Lund, J.J.; Stratman, E.J.; Jose, D.; Xia, L.; Wilson, D.; Moizuddin, M. Drug-induced bullous Seet syndrome with multiple autoimmune features. Autoimmune Dis. 2010, 2010, 176479. [Google Scholar]
- Arun Kumar, A.U.; Elsayed, M.E.; Alghali, A.; Ali, A.A.; Mohamed, H.; Hussein, W.; Hackett, C.; Leonard, N.; Stack, A.G. Sweet syndrome: A rare feature of ANCA-associated vasculitis or unusual consequence of azathioprine-induced treatment. Allergy Asthma Clin. Immunol. 2018, 14, 46. [Google Scholar] [CrossRef]
- Kasirye, Y.; Danhof, R.S.; Epperla, N.E.; Garcia-Montilla, R.J. Sweet’s syndrome: One disease, multiple faces. Clin. Med. Res. 2011, 9, 134–136. [Google Scholar] [CrossRef]
- Bodard, Q.; Carre, D.; Chenal, P.; Zarnitsky, C.; Midhat, M.; Litrowski, N. Drug-induced related to hydroxychloroquine: About 2 cases. Rev. Med. Interne 2019. [Google Scholar] [CrossRef]
- Chen, X.; Wu, H.; Wei, W. Advances in the diagnosis and treatment of Sjogren’s syndrome. Clin. Rheumatol. 2018, 37, 1743–1749. [Google Scholar] [CrossRef]
- Maślińska, M.; Przygodzka, M.; Kwiatkowska, B.; Sikorska-Siudek, K. Sjögren’s syndrome: Still not fully understood disease. Rheumatol. Int. 2015, 35, 233–241. [Google Scholar] [CrossRef] [PubMed]
- Shiboski, C.H.; Shiboski, S.C.; Seror, R.; Criswell, L.A.; Labetoulle, M.; Lietman, T.M.; Rasmussen, A.; Scofield, H.; Vitali, C.; Bowman, S.J.; et al. 2016 American College of Rheumatology/European League Against Rheumatism classification criteria for primary Sjögren’s syndrome: A consensus and data-driven methodology involving three international patient cohorts. Ann. Rheum. Dis. 2017, 69, 35–45. [Google Scholar]
- Franceschini, F.; Cavazzana, I.; Andreoli, L.; Tincani, A. The 2016 classification criteria for primary Sjogren’s syndrome: what’s new? BMC Med. 2017, 15, 69. [Google Scholar] [CrossRef] [PubMed]
- Seror, R.; Bowman, S.J.; Brito-Zeron, P.; Theander, E.; Bootsma, H.; Tzioufas, A.; Gottenberg, J.-E.; Ramos-Casals, M.; Dorner, T.; Ravaud, P.; et al. EULAR Sjögren’s syndrome disease activity index (ESSDAI): A user guide. RMD Open 2015, 1, e000022. [Google Scholar] [CrossRef] [PubMed]
- Manzo, C.; Maslinska, M. Primary Sjögren’s syndrome in the elderly: Does age of onset make a difference? EMJ Rheumatol. 2018, 5, 75–82. [Google Scholar]
- Botsios, C.; Furlan, A.; Ostuni, P.; Sfriso, P.; Andretta, M.; Ometto, F.; Raffeiner, B.; Todesco, S.; Punzi, L. Elderly onset of primary Sjögren’s syndrome: Clinical manifestations, serological features and oral/ocular diagnostic tests. Comparison with adult and young onset of the disease in a cohort of 336 Italian patients. Jt. Bone Spine 2011, 78, 171–174. [Google Scholar] [CrossRef]
- Chebbi, W.; Ben Salem, W.; Klii, R.; Kessomtini, W.; Jerbi, S.; Sfar, M.H. Primitive Sjögren syndrome in the elderly: Clinical and immunological characteristics. Pan Afr. Med. J. 2015, 20, 8. [Google Scholar] [CrossRef]
- Von den Driesch, P. Sweet’s syndrome (acute febrile neutrophilic dermatosis). J. Am. Acad. Dermatol. 1994, 31, 535–556. [Google Scholar] [CrossRef]
- Levenstein, M.M.; Fisher, B.K.; Fisher, L.L.; Pruzanski, W. Simultaneous occurrence of subacute cutaneous lupus erythematosus and Sweet syndrome. A marker of Sjögren syndrome? Int. J. Dermatol. 1991, 30, 640–643. [Google Scholar] [CrossRef]
- Bianconcini, G.; Mazzali, F.; Candini, R.; Dallasta, A.; Gobbi, F. Sweet’s syndrome (acute febrile neutrophilic dermatosis) associated with Sjögren’s syndrome. A clinical case. Minerva Med. 1991, 82, 869–876. [Google Scholar]
- Osawa, H.; Yamabe, H.; Seino, S.; Fukushi, K.; Miyata, M.; Inuma, H.; Kaizuka, M.; Tamura, N.; Tsunoda, S.; Baba, Y. A case of Sjögren’s syndrome associated with Sweet’s syndrome. Clin. Rheumatol. 1997, 16, 101–105. [Google Scholar] [CrossRef] [PubMed]
- Vatan, R.; Sire, S.; Constans, J.; Ragnaud, J.M. Association of primary Gougerot-Sjögren syndrome and Sweet syndrome. Apropos of a case. Rev. Med. Interne 1997, 18, 734–735. [Google Scholar] [CrossRef]
- Harada, Y.; Egi, Y.; Honda, Y.; Shirota, T.; Hayashi, T. Multiple myeloma with Sweet disease developing from monoclonal gammopathy of undetermined significance and Sjögren syndrome. Rinsho Ketsueki 2001, 42, 1176–1180. [Google Scholar] [PubMed]
- Foster, E.N.; Nguyen, K.K.; Sheikh, R.A.; Prindiville, T.P. Crohn’s disease associated with Sweet’s syndrome and Sjögren’s syndrome treated with infliximab. Clin. Dev. Immunol. 2005, 12, 145–149. [Google Scholar] [CrossRef] [PubMed]
- Souissi, A.; Benmously, R.; Fenniche, S.; Zarrouk, M.; Marrek, H.; Debbiche, A.; Ayed, M.B.; Mokhtar, I. Sweet’s syndrome: A propos of 8 cases. Tunis. Med. 2007, 85, 49–53. [Google Scholar] [PubMed]
- Mrabet, D.; Saadi, F.; Zaraa, I.; Chelly, I.; Sahli, H.; Osmane, A.-B.; Meddeb, N.; Sellami, S. Sweet’s syndrome in a patient with rheumatoid arthritis, Sjögren’s syndrome and lymph node tuberculosis. BMJ Case Rep. 2011, 2011, pii:bcr0720103137. [Google Scholar] [CrossRef]
- Walker, D.C.; Cohen, P.R. Trimethoprim-sulfamethoxazole-associated acute febrile neutrophilic dermatosis: Case report and review of drug-induced Sweet’s syndrome. J. Am. Acad. Dermatol. 1996, 34, 918–923. [Google Scholar] [CrossRef]
- Wang, S.Q.; Zhang, L.W.; Hua, H. Is hydroxychloroquine effective in treating primary Sjogren’s syndrome: A systematic review and meta-analysis. BMC Musculoskelet. Disord. 2017, 18, 186. [Google Scholar] [CrossRef]
- Ktulze, A.A.; Hene, R.J.; Kallenberg, C.G.; van Bijsterveld, O.P.; van der Heide, A.; Kater, L.; Bijlsma, J.W. Hydroxychloroquine treatment for primary Sjogren’s syndrome: A two year double blind crossover trial. Ann. Rheum. Dis. 1993, 52, 360–364. [Google Scholar]
- Haladyi, E.; Sikora, M.; Felis-Giemza, A.; Oleslnka, M. Antimalarials. Are they effective and safe in rheumatic diseases? Reumatologia 2018, 56, 164–173. [Google Scholar] [CrossRef]
- Manzo, C.; Gareri, P.; Castagna, A. Psychomotor agitation following treatment with hydroxychloroquine. Drug Saf. Case Rep. 2017, 4, 6. [Google Scholar] [CrossRef] [PubMed]
- Skare, T.; Ferrari Ribeiro, C.; Souza, F.H.M.; Haendchen, L.; Jordao, J.M. Antimalarials cutaneous side effects:a study in 209 users. Cutan. Ocul. Toxicol. 2010, 30, 45–49. [Google Scholar] [CrossRef] [PubMed]
- Naranjo, C.A.; Busto, U.; Sellers, E.M.; Sandor, P.; Ruiz, I.; Robert, E.A.; Janecek, E.; Domecq, C.; Greenblatt, D.J. A method for estimating the probability of adverse drug reaction. Clin. Pharmacol. Ther. 1981, 30, 239–245. [Google Scholar] [CrossRef] [PubMed]
- Tett, S.E.; Cutler, D.J.; Day, R.O.; Brown, K.F. Bioavailability of hydroxychloroquine tablets in healthy volunteers. Br. J. Clin. Pharmacol. 1989, 27, 771–779. [Google Scholar] [CrossRef]

| Major Criteria |
|
|
| Minor Criteria |
|
|
|
|
| First Author | Year of Publication | pSS | HCG | sSS | Sweet’s Syndrome? |
|---|---|---|---|---|---|
| Levenstein MM [19] | 1991 | NO | NO | YES | Probably no. Annular erythema. |
| Bianconcini G [20] | 1991 | NO | NO | YES | Unclear data |
| Osawa H [21] | 1997 | NO | NO | YES | YES |
| Vatan R [22] | 1997 | YES | NO | NO | YES |
| Harada Y [23] | 2001 | NO | NO | YES | YES |
| Foster EN [24] | 2005 | NO | NO | YES | YES |
| Souissi A [25] | 2007 | NO | NO | YES | YES |
| Mrabet D [26] | 2011 | NO | NO | YES | YES |
| Bodard Q [6] | 2019 | NO | YES | YES | YES |
|
|
|
|
|
| Yes | No | Do Not Know | Score | |
|---|---|---|---|---|
| 1. Are there previous conclusive reports on this reaction? | +1 | 0 | 0 | +1 |
| 2. Did the adverse event appear after the suspected drug was administered? | +2 | −1 | 0 | +2 |
| 3. Did the adverse reaction improve when the drug was discontinued or a specific antagonist was administered? | +1 | 0 | 0 | +1 |
| 4. Did the adverse reaction reappear when the drug was readministered? | +2 | −1 | 0 | 2 |
| 5. Are there alternative causes (other than the drug) that could on their own have caused the reaction? | −1 | +2 | 0 | +2 |
| 6. Did the reaction reappear when a placebo was given? | −1 | +1 | 0 | 0 |
| 7. Was the drug detected in the blood (or other fluids) in concentrations known to be toxic? | +1 | 0 | 0 | 0 |
| 8. Was the reaction more severe when the dose was increased, or less severe when the dose was decreased? | +1 | 0 | 0 | 1 |
| 9. Did the patient have a similar reaction to the same or similar drugs in any previous exposure? | +1 | 0 | 0 | 0 |
| 10. Was the adverse event confirmed by any objective evidence? | +1 | 0 | 0 | 1 |
| Total | Score | 10 |
© 2019 by the authors. Licensee MDPI, Basel, Switzerland. This article is an open access article distributed under the terms and conditions of the Creative Commons Attribution (CC BY) license (http://creativecommons.org/licenses/by/4.0/).
Share and Cite
Manzo, C.; Pollio, N.; Natale, M. Sweet’s Syndrome Following Therapy with Hydroxychloroquine in a Patient Affected with Elderly-Onset Primary Sjogren’s Syndrome. Medicines 2019, 6, 111. https://doi.org/10.3390/medicines6040111
Manzo C, Pollio N, Natale M. Sweet’s Syndrome Following Therapy with Hydroxychloroquine in a Patient Affected with Elderly-Onset Primary Sjogren’s Syndrome. Medicines. 2019; 6(4):111. https://doi.org/10.3390/medicines6040111
Chicago/Turabian StyleManzo, Ciro, Nazareno Pollio, and Maria Natale. 2019. "Sweet’s Syndrome Following Therapy with Hydroxychloroquine in a Patient Affected with Elderly-Onset Primary Sjogren’s Syndrome" Medicines 6, no. 4: 111. https://doi.org/10.3390/medicines6040111
APA StyleManzo, C., Pollio, N., & Natale, M. (2019). Sweet’s Syndrome Following Therapy with Hydroxychloroquine in a Patient Affected with Elderly-Onset Primary Sjogren’s Syndrome. Medicines, 6(4), 111. https://doi.org/10.3390/medicines6040111

